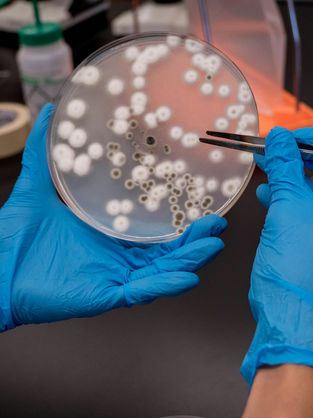
Paradigm Shift in Microbiological Testing: Why the FDA Recommends Adopting Rapid Microbiological Methods (RMM) in Parallel

AI Deep Learning
Sensor-on-a-Chip
for Water Quality & Bacteria
The.Wave.Talk presents a water monitoring sensor with optical path amplification technology, significantly surpassing existing limitations. This innovative sensor accurately quantifies all foreign substances in water—from turbidity to bacteria and pathogens— at 1/10th the size and disruptive cost innovation of conventional sensors without any compromise on performance.
We envision universal access to clean water through the democratization of water quality monitoring.

Key Features
Effortless and Seamless
Water Quality Monitoring
01 Accessibility
Less Maintenance,
More Monitoring
Our world's first maintenance-free turbidimeter requires no cleaning or calibration for up to 10 years, remaining unaffected by water scaling, scratches, and biofilm. Equipped with IoT technology and accessible via a web or mobile app, it simplifies water quality management for even extensive data sets, such as those from membrane cells.
02 Affordability
Miniature Size,
Maximum Cost-efficiency
By integrating the core components(laser and camera) into a single-chip ASIC, we've created a sensor that is 1/10th the size and disruptive cost reduction compared to competitors' Table-Top and In-Line turbidimeters. This enables the installation of turbidimeters inside small household appliances (such as water purifiers and humidifiers), allowing for real-time water quality checks. Additionally, it requires no extra maintenance costs or specialized staff, ensuring cost-effective operation.
03 Performance
Quick and Correct
in Every Pulse
Despite its affordable price and compact size, it maintains accuracy on par with other professional turbidimeters. It can measure water turbidity in just 10 seconds without requiring any experimental apparatus. Not just for laboratories or experts, it ensures accurate and consistent measurement, enabling the acquisition of high-quality data.

Core Technology
The.Wave.Talk has surpassed the limitations of existing turbidity sensors with its core technology. Through our patented hardware, CSMS™ (Chaotic Scattering Material and Structure), we elongate optical path lengths through the measurement sample and precisely analyze the concentration of impurities regardless of the light source or measurement environment, using AI technology for scattering signal analysis. By integrating all these technologies through ASIC development, we offer sensors that are cost-competitive and compact, making them applicable to any industry.
Impurity
0.1mm
Bacteria
1μm
Applicable Area
Digitized Water for
Full-cycle Water Management
Now, water quality can be measured and shared anywhere, just like any other data. Our goal is to provide reliable data at every point related to water quality, at a competitive price. The affordable price, compact size, and the semi-permanent nature of the sensor enable its application across the entire water supply chain, from source to user. By continuously monitoring water turbidity, it can detect changes in the concentration of fine particles and identify contamination, allowing for prompt and appropriate responses. This significantly enhances the efficiency of water quality management systems and leads to cost savings in maintenance.
Our Products
Product Range Tailored to
Different Environments and Needs
01 Turbidity Meter
02 Bacteria and Pathogen
COLLABORATION
Our Industry Partners
.png)

.jpg)